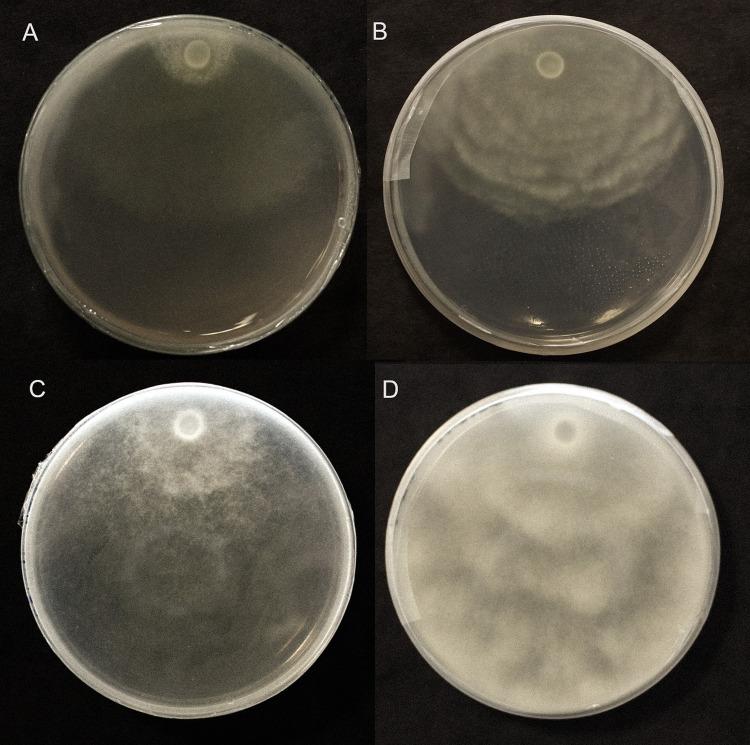
https://cdn.ncbi.nlm.nih.gov/pmc/blobs/de64/10896519/9fbc6b3fdd0f/pone.0298514.g006.jpg

内生假单胞菌IALR1619 对黄瓜和水培生菜两种腐霉的生物防治潜力。
Biocontrol potential of endophytic Pseudomonas strain IALR1619 against two Pythium species in cucumber and hydroponic lettuce.
机构信息
The Institute for Advanced Learning and Research, The Plant Endophyte Research Center, Danville, VA, United States of America.
School of Plant and Environmental Sciences-Virginia Tech at The Institute for Advanced Learning and Research, Controlled Environment Agriculture Innovation Center, Danville, VA, United States of America.
出版信息
PLoS One. 2024 Feb 26;19(2):e0298514. doi: 10.1371/journal.pone.0298514. eCollection 2024.
The use of fungicides to manage disease has led to multiple environmental externalities, including resistance development, pollution, and non-target mortality. Growers have limited options as legacy chemistry is withdrawn from the market. Moreover, fungicides are generally labeled for traditional soil-based production, and not for liquid culture systems. Biocontrol agents for disease management are a more sustainable and environmentally friendly alternative to conventional agroprotectants. Pythium ultimum is a soil borne oomycete plant pathogen with a broad taxonomic host range exceeding 300 plants. Cucumber seedlings exposed to P. ultimum 1 day after a protective inoculation with bacterial endophyte accession IALR1619 (Pseudomonas sp.) recorded 59% survival; with the control assessed at 18%. When the pathogen was added 5 days post endophyte inoculation, 74% of the seedlings treated survived, compared to 36% of the control, indicating a longer-term effect of IALR1619. Under hydroponic conditions, IALR1619 treated leaf type lettuce cv. 'Cristabel' and Romaine cv. 'Red Rosie' showed 29% and 42% higher shoot fresh weight compared to their controls, respectively. Similar results with less growth decline were observed for a repeat experiment with IALR1619. Additionally, an experiment on hydroponic lettuce in pots with perlite was carried out with a mixture of P. ultimum and P. dissotocum after IALR1619 inoculation. The endophyte treated 'Cristabel' showed fresh weight gain, but the second cultivar 'Pensacola' yielded no increase. In summary, the endophyte IALR1619 provided short term as well as medium-term protection against Pythium blight in cucumber seedlings and may be used as an alternative to conventional fungicides in a greenhouse setting. This study also demonstrated the potential of ALR1619 as a biocontrol agent against Pythium blight in hydroponic lettuce.
杀菌剂的使用在管理疾病方面带来了多种环境外部性,包括抗药性发展、污染和非靶标死亡率。随着传统化学物质从市场上撤出,种植者的选择有限。此外,杀菌剂通常被标记为传统的基于土壤的生产,而不是液体培养系统。生物防治剂是一种比传统农业保护剂更可持续和环保的替代方法。腐霉是一种土壤传播的卵菌植物病原体,其分类宿主范围广泛,超过 300 种植物。在黄瓜幼苗中,在保护性接种细菌内生菌IALR1619(假单胞菌)1 天后暴露于腐霉中,记录到 59%的存活率;而对照为 18%。当病原体在内生菌接种后 5 天添加时,74%的幼苗存活,而对照为 36%,表明IALR1619 的作用时间更长。在水培条件下,IALR1619 处理的生菜叶型品种“Cristabel”和罗马生菜品种“Red Rosie”的鲜重分别比对照高 29%和 42%。在重复实验中,IALR1619 也观察到了类似的结果,但生长下降幅度较小。此外,在使用珍珠岩的盆栽水培生菜实验中,在接种IALR1619 后,将腐霉和 dissotocum 混合。内生菌处理的“Cristabel”表现出鲜重增加,但第二个品种“Pensacola”没有增加。总之,内生菌 IALR1619 为黄瓜幼苗提供了短期和中期的腐霉疫病保护,并且可以作为温室中传统杀菌剂的替代品。本研究还表明,IALR1619 作为一种生物防治剂在水培生菜中防治腐霉疫病具有潜力。